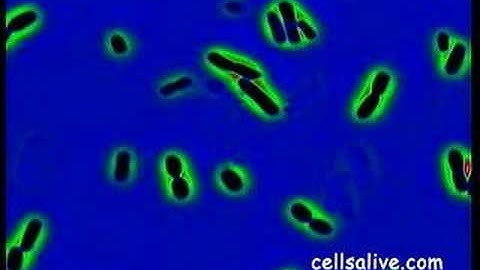

⬇ DOWNLOAD NOW
Kalau muncul iklan pop-up, tutup lalu klik tombol kembali
Download lagu E. coli Cells Explode secara gratis hanya untuk keperluan promosi. Dukung artis favorit kamu dengan membeli musik original di iTunes atau platform resmi lainnya.
 Exploding E. coli
Exploding E. coli
 Exploding bacteria with penicillin
Exploding bacteria with penicillin
 bacteriophage vs ecoli animation
bacteriophage vs ecoli animation
 Macrophage in action vs E. coli: MOA Animation of Phagocytosis, a fundamental immunological process
Macrophage in action vs E. coli: MOA Animation of Phagocytosis, a fundamental immunological process
 T4 Phage attacking E.coli
T4 Phage attacking E.coli
Bacteriophage T-4 Kills E. coli Bacteria
Bacteriophage T-4 Kills E. coli Bacteria
 E.coli bacterium movement under microscope #ecoli #microscopy #bacteria #science #biology
E.coli bacterium movement under microscope #ecoli #microscopy #bacteria #science #biology
 Penicillin Causing Bacteria to EXPLODE!
Penicillin Causing Bacteria to EXPLODE!